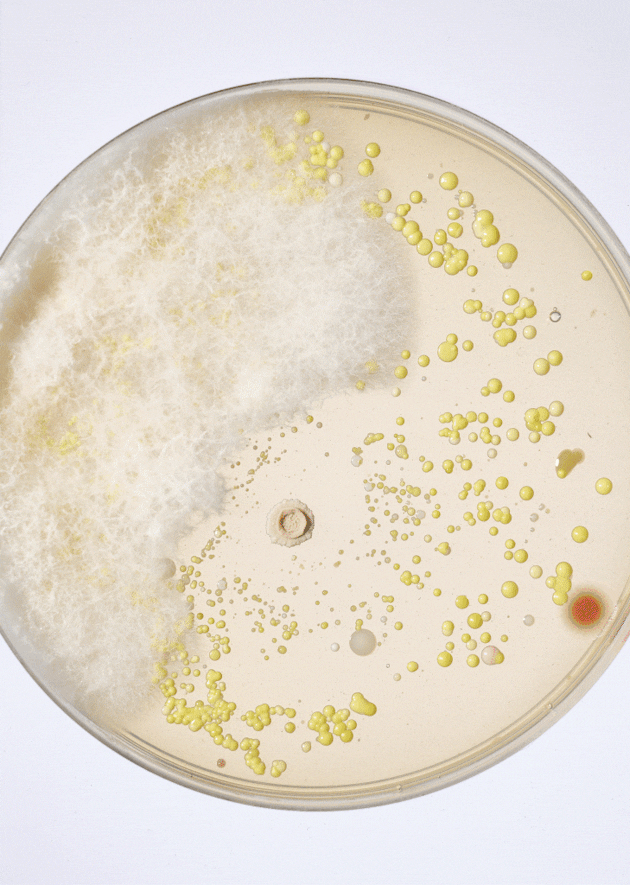
No alternate text
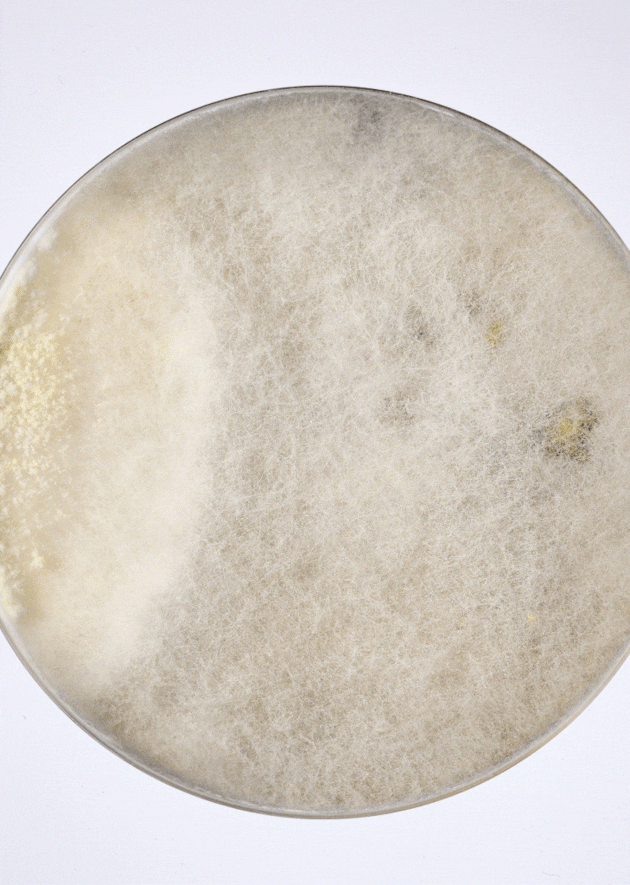
No alternate text
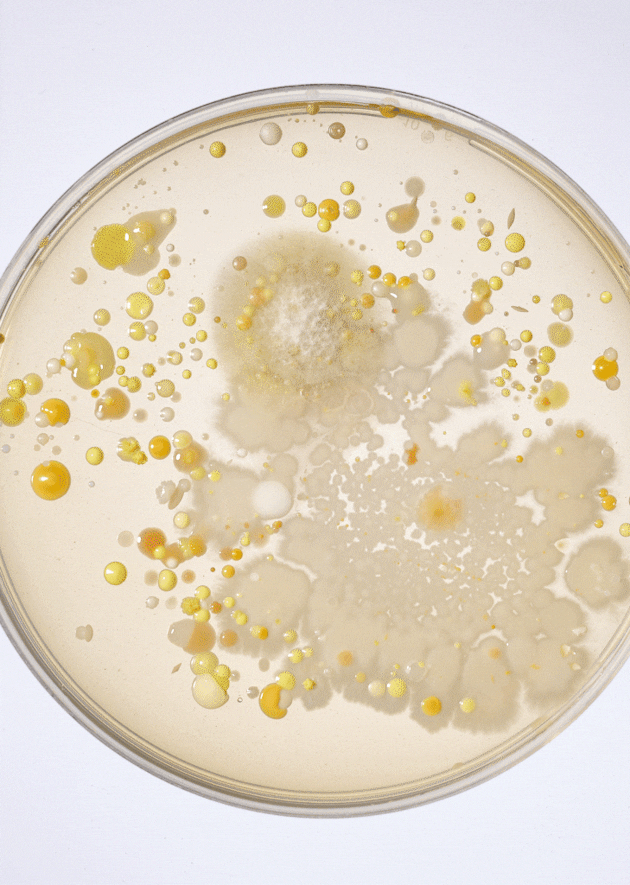
No alternate text
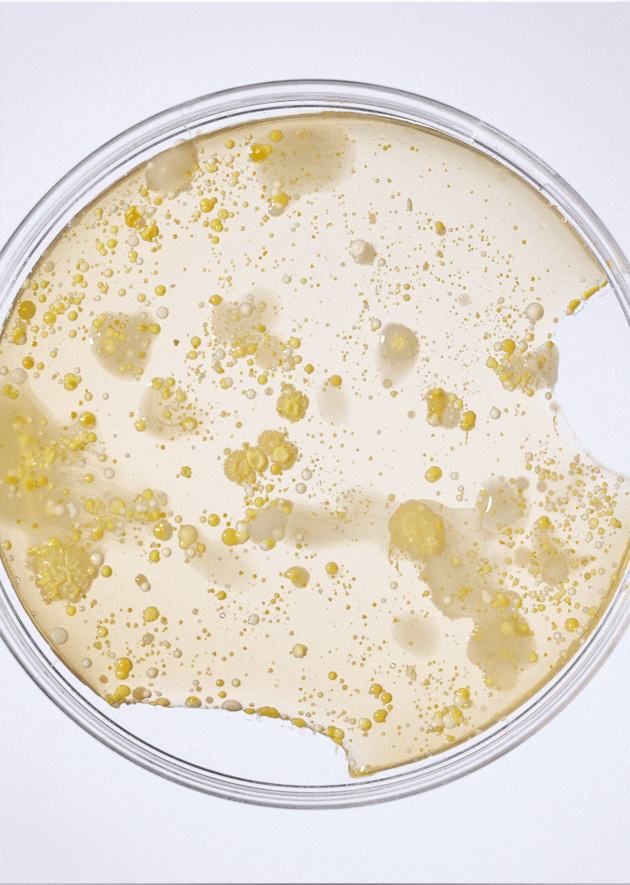
No alternate text
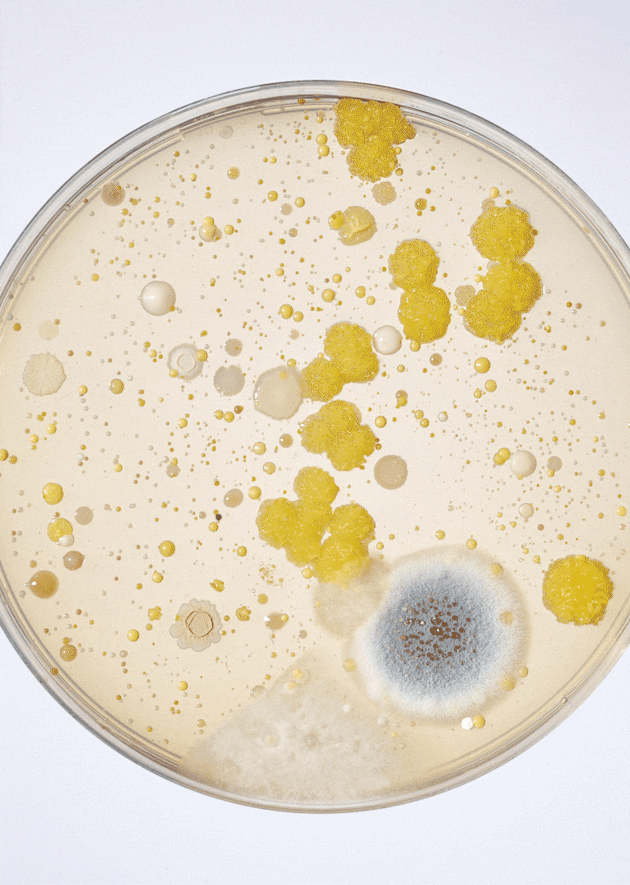
No alternate text
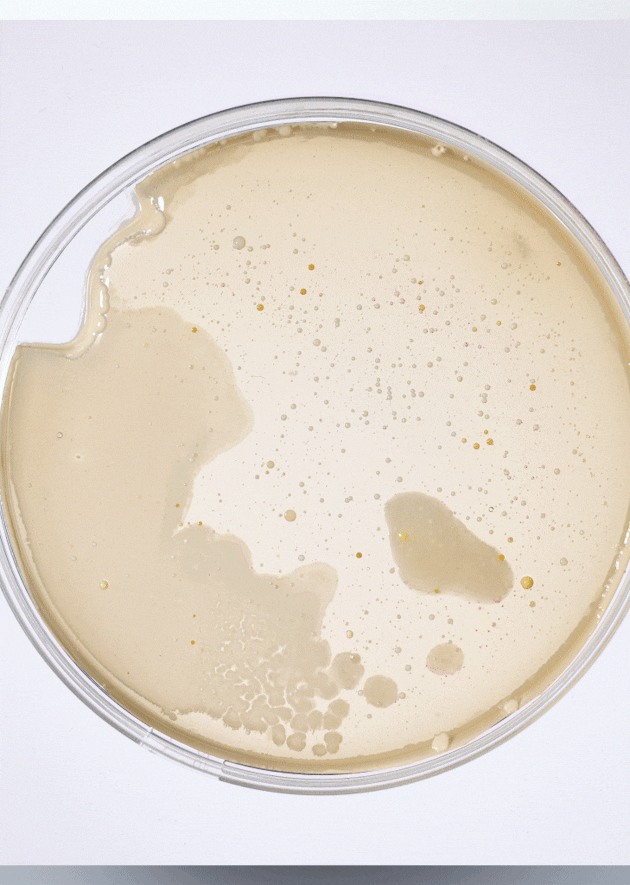
No alternate text
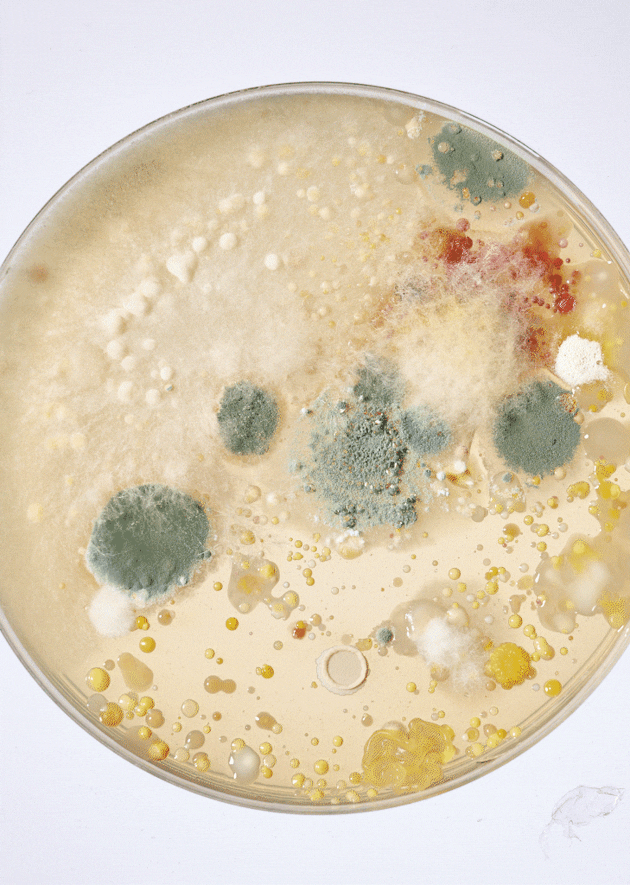
No alternate text
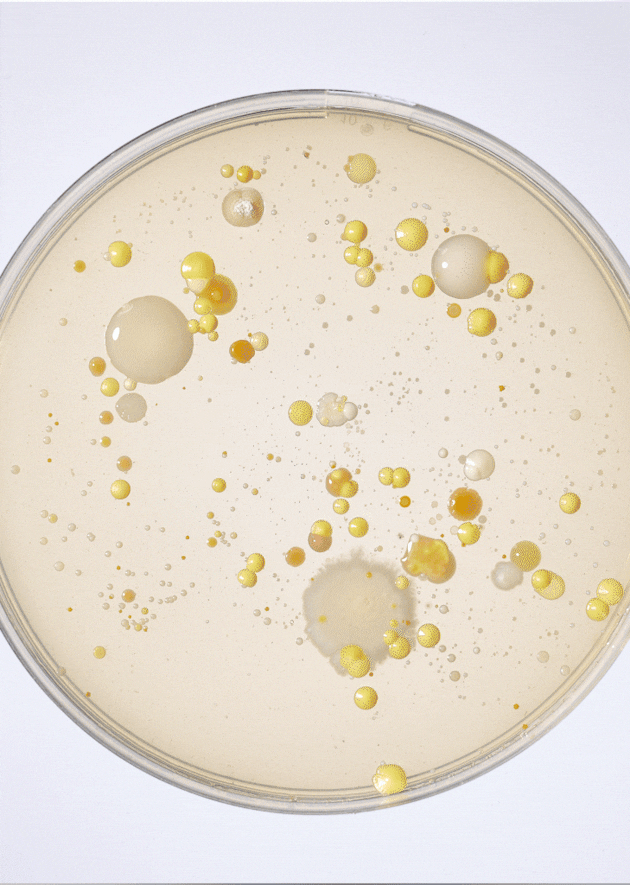
No alternate text
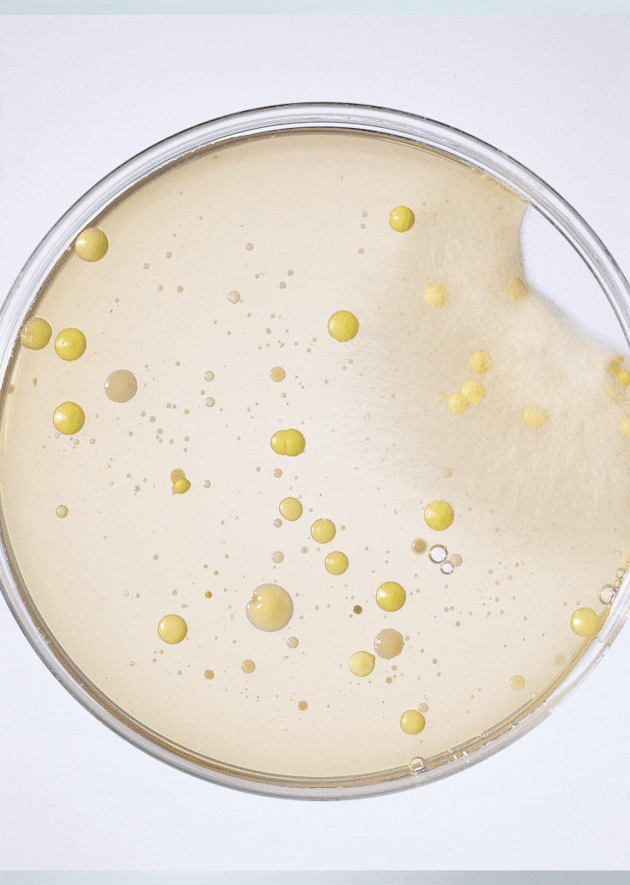
No alternate text
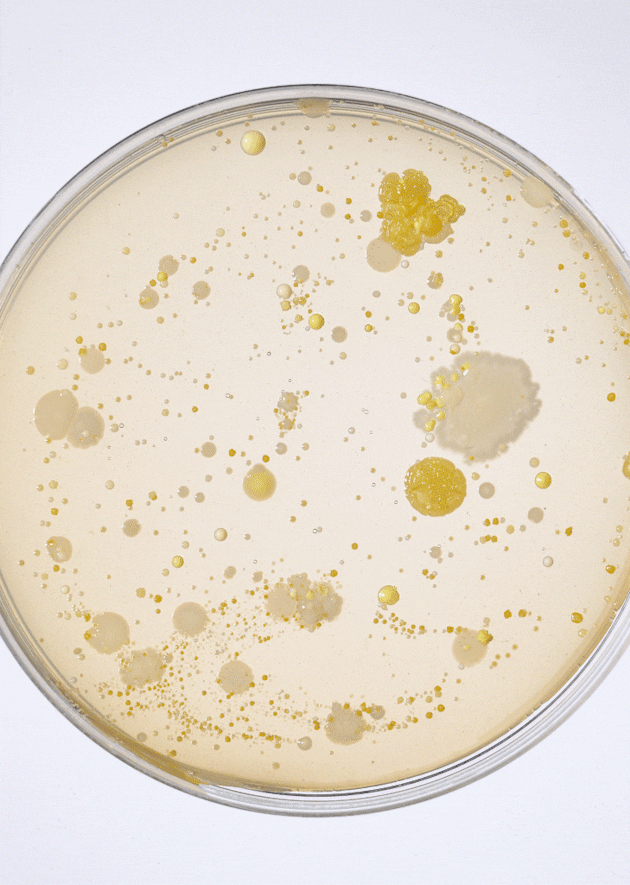
No alternate text
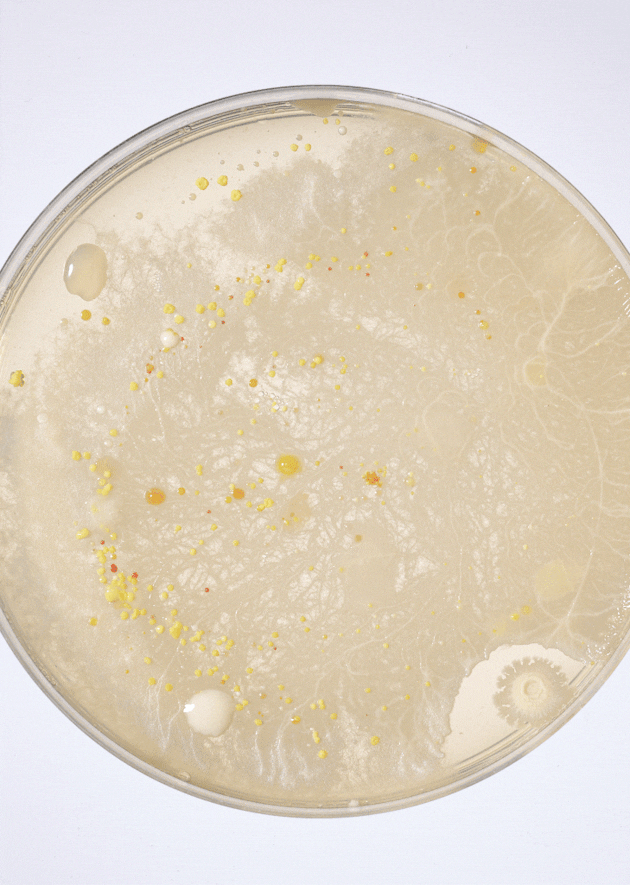
No alternate text
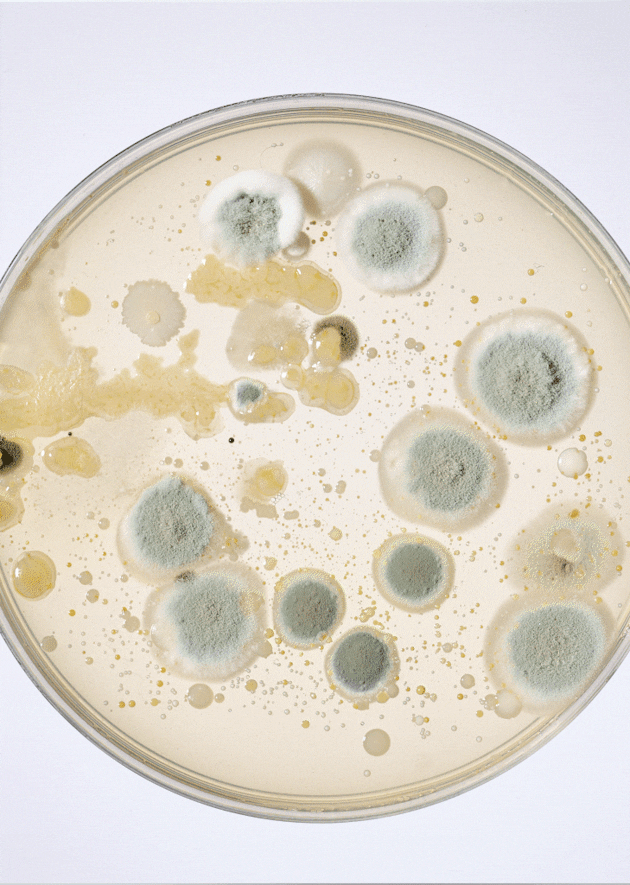
No alternate text
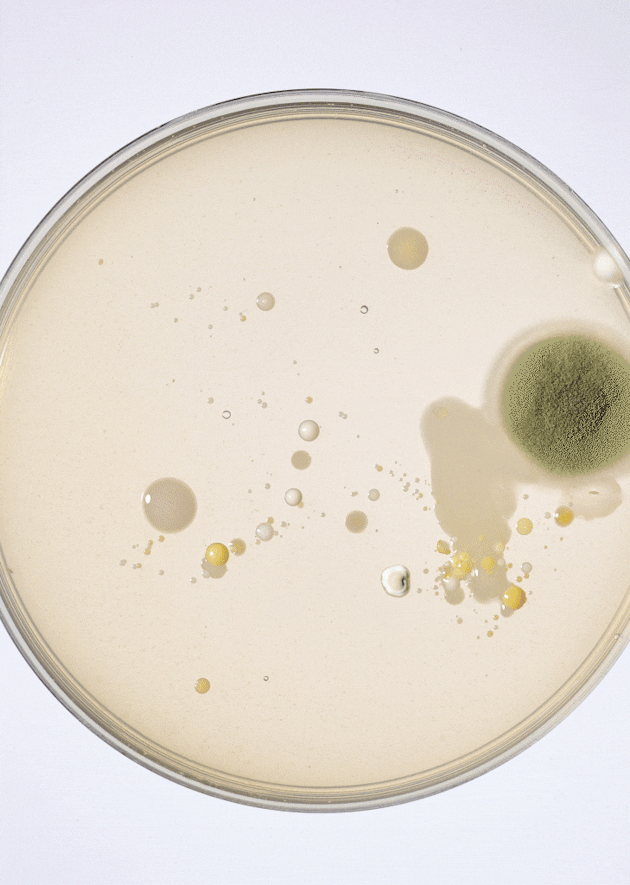
No alternate text
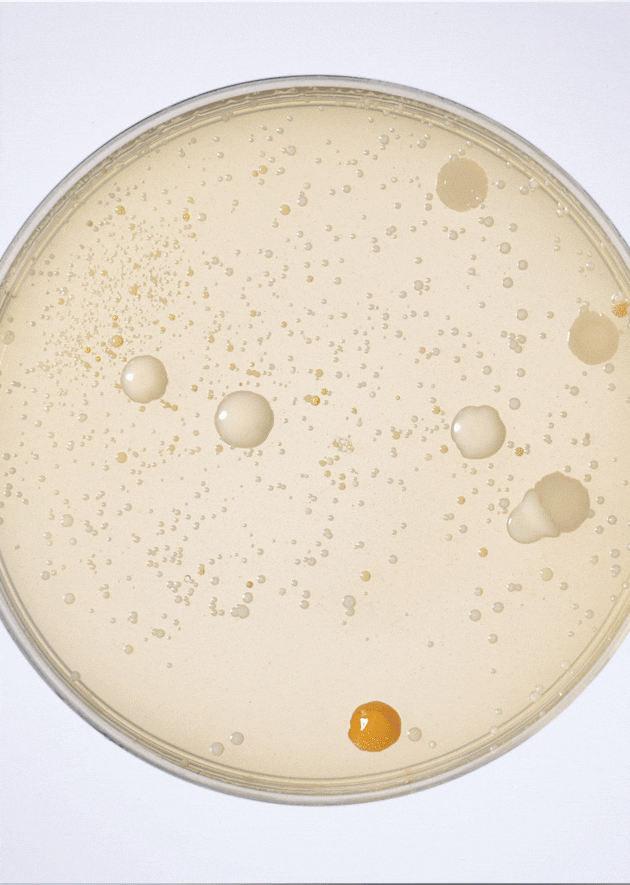
No alternate text
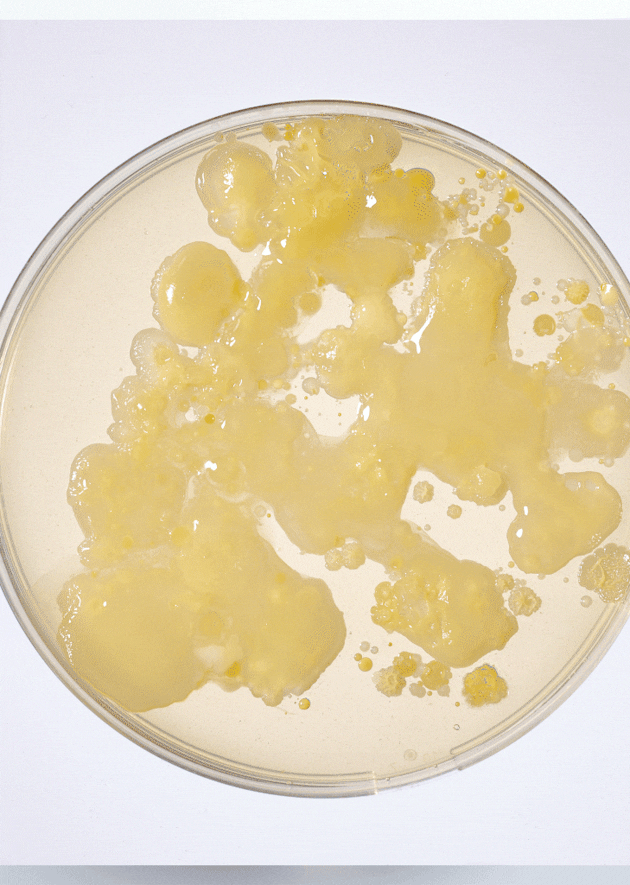
No alternate text
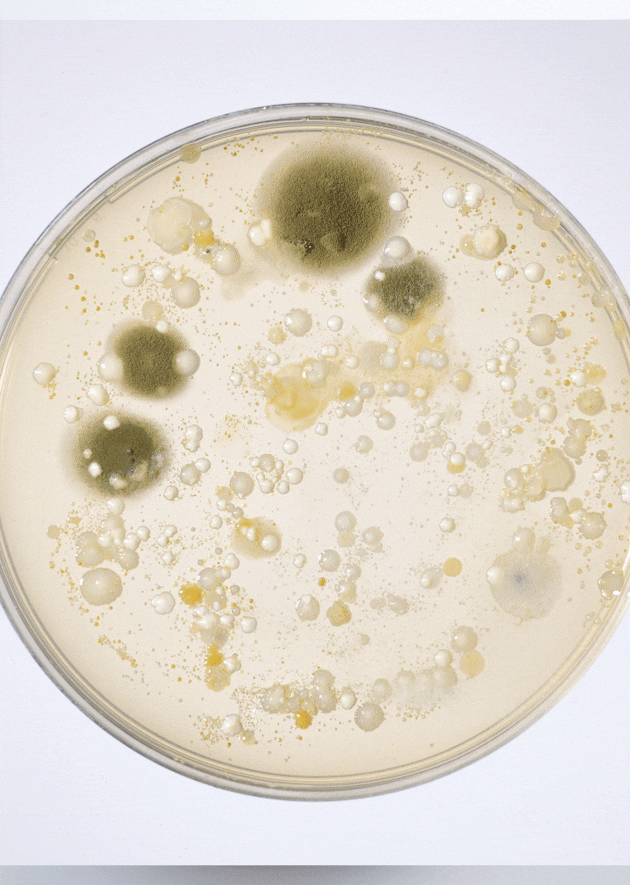
No alternate text
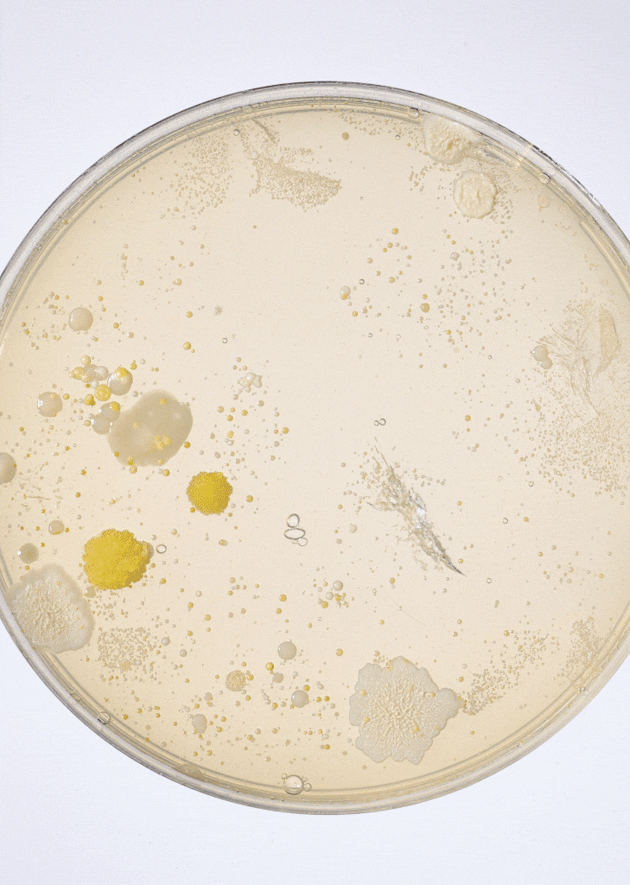
No alternate text
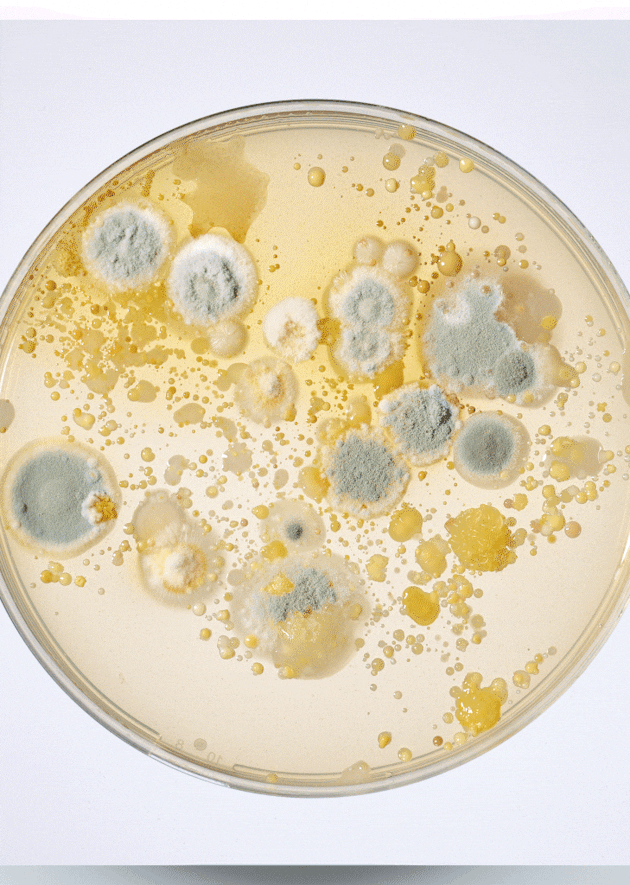
No alternate text
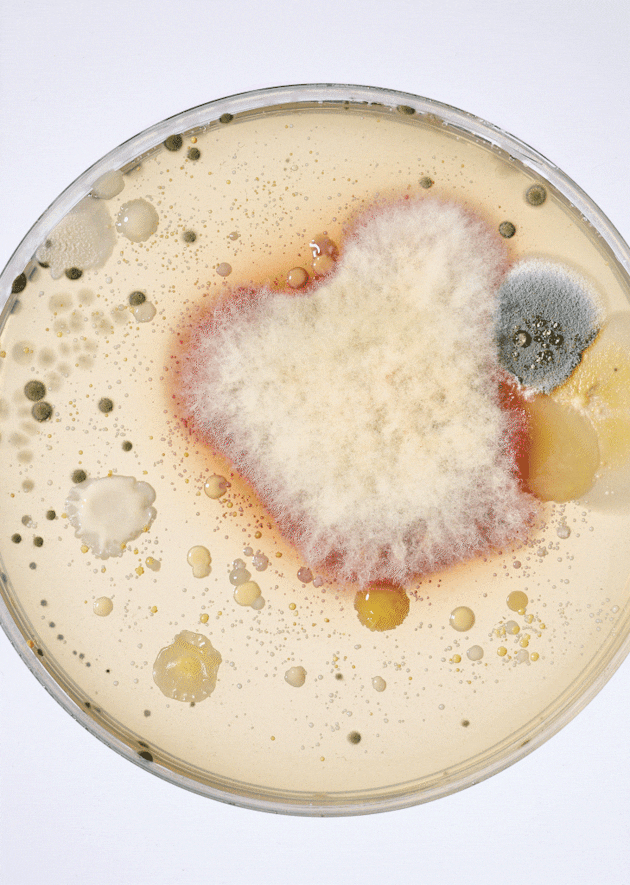
No alternate text
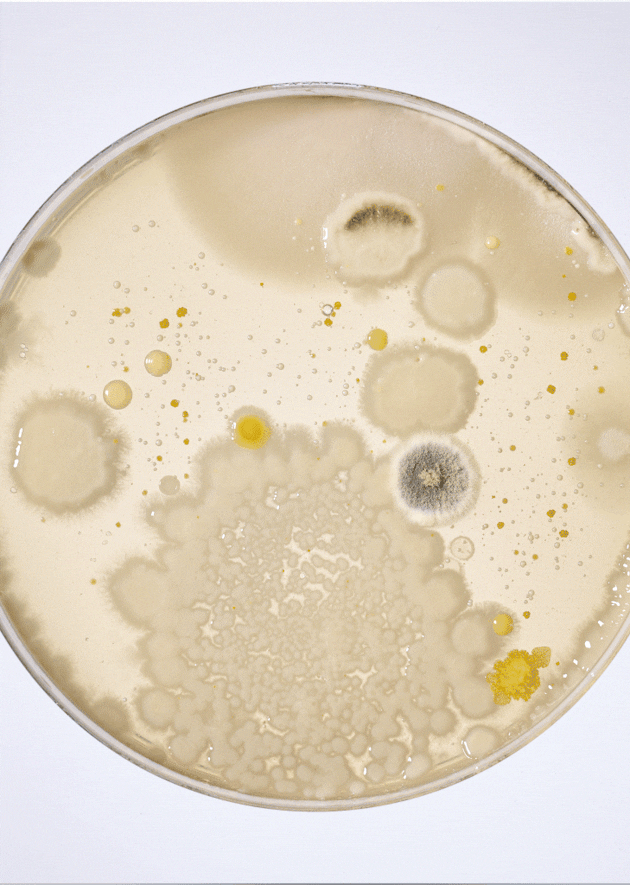
No alternate text
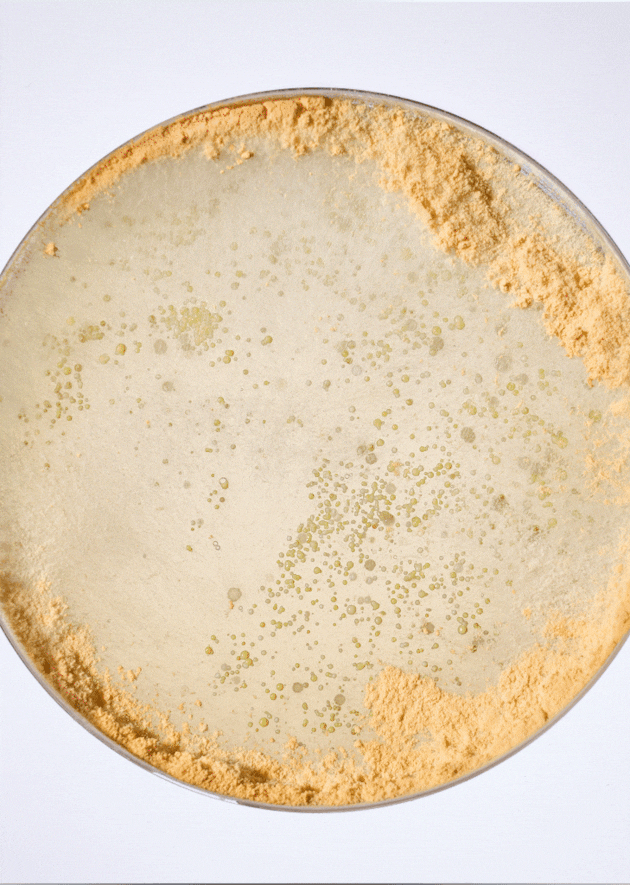
No alternate text
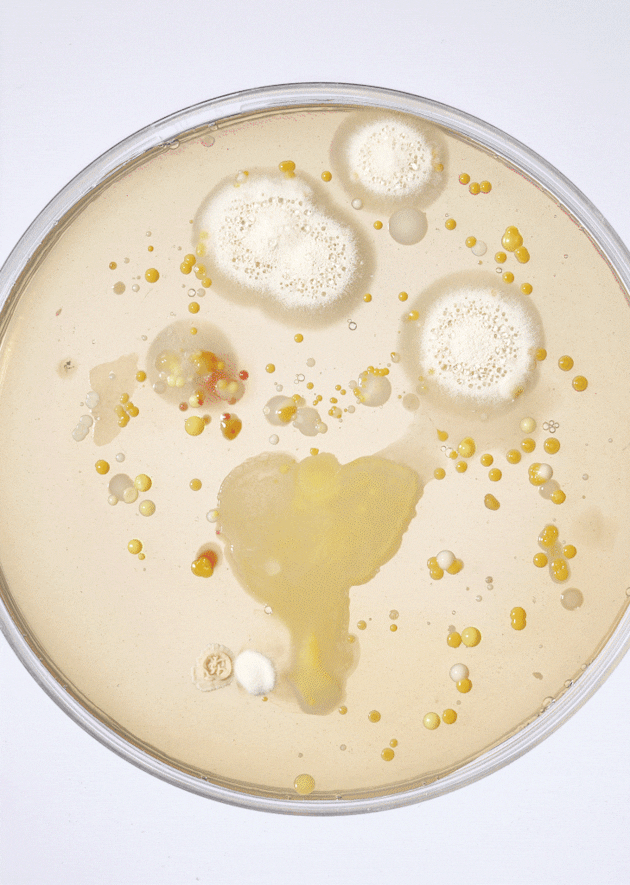
No alternate text
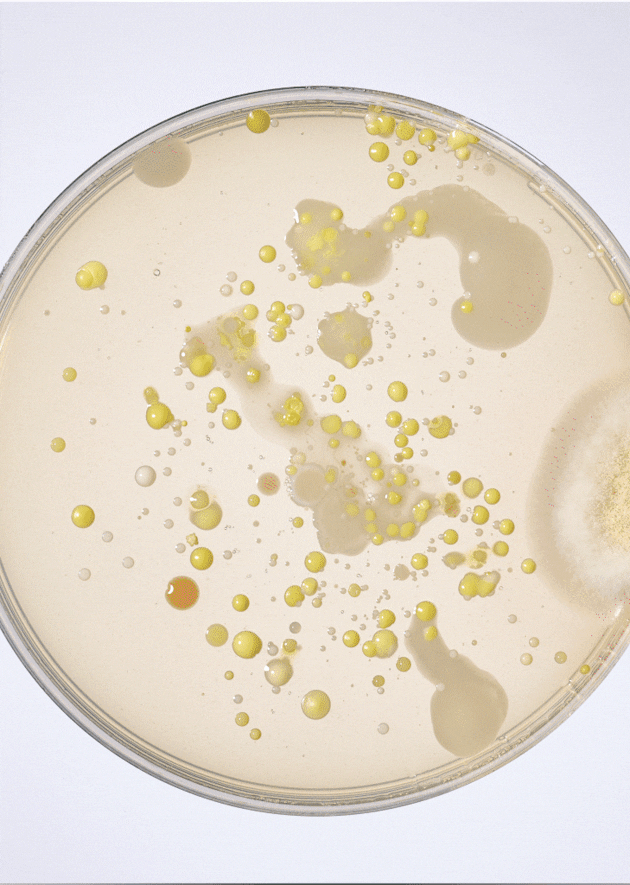
No alternate text
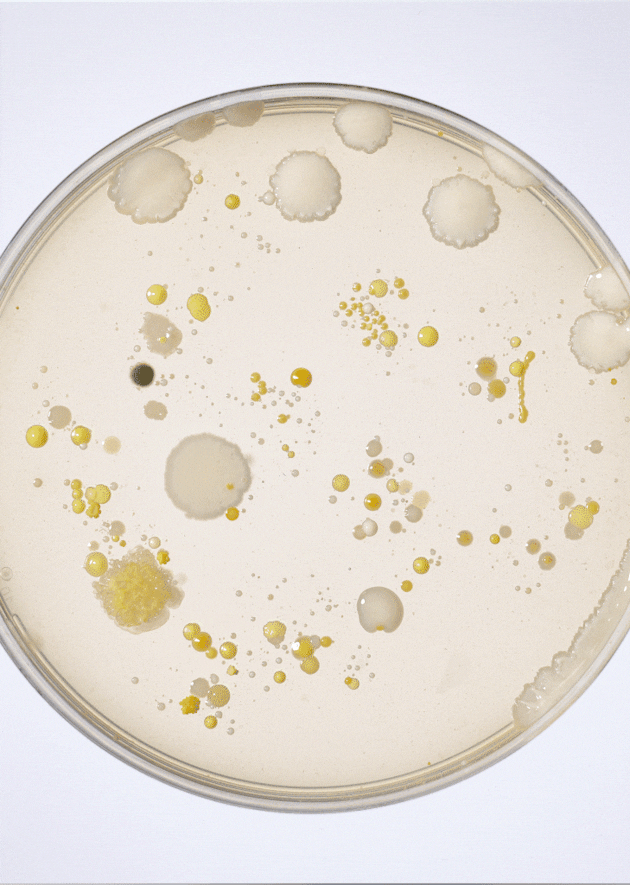
No alternate text
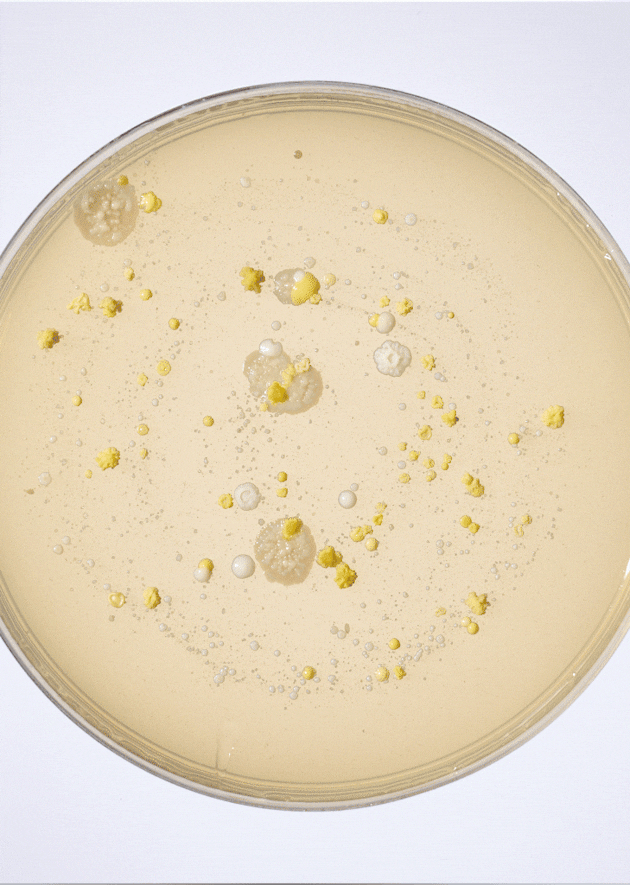
No alternate text
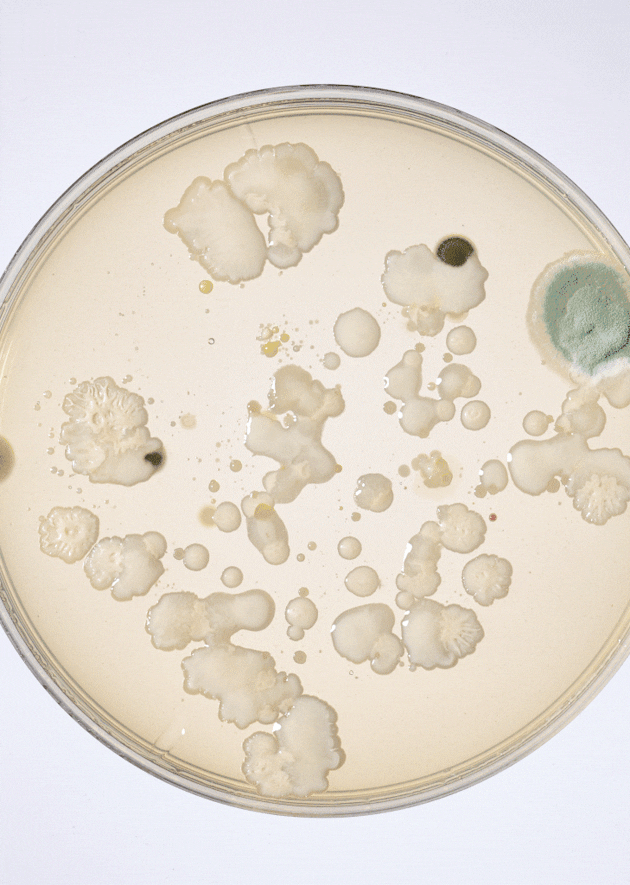
No alternate text
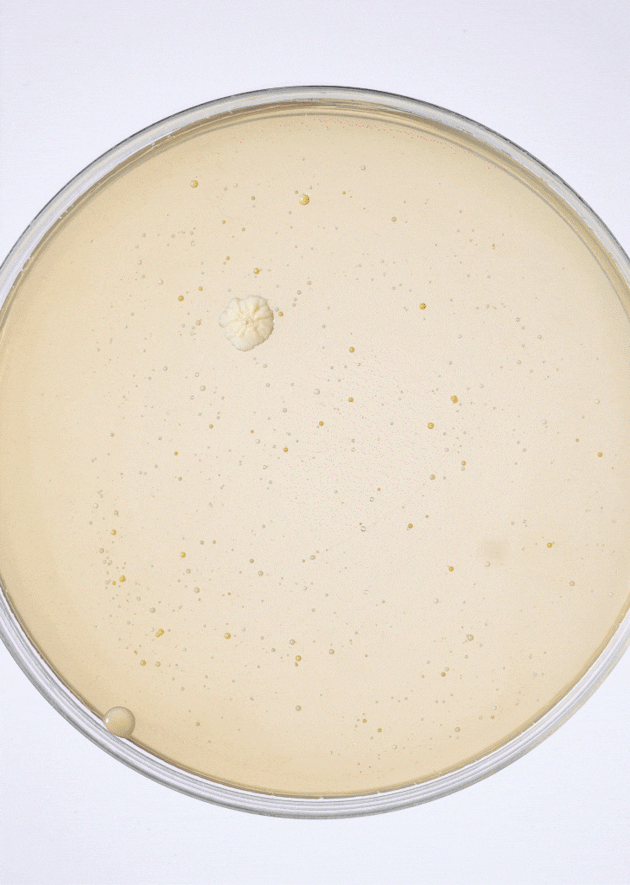
No alternate text
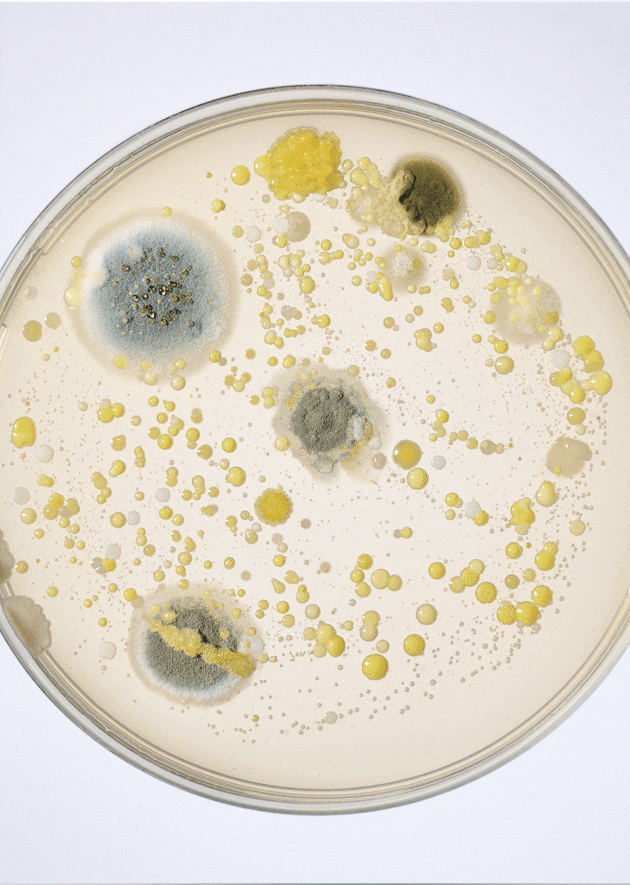
No alternate text
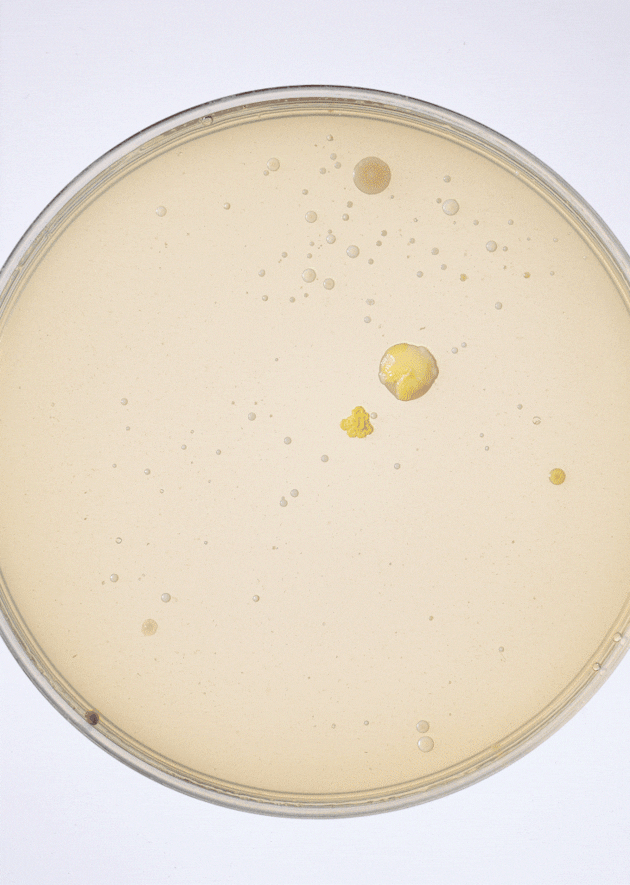
No alternate text
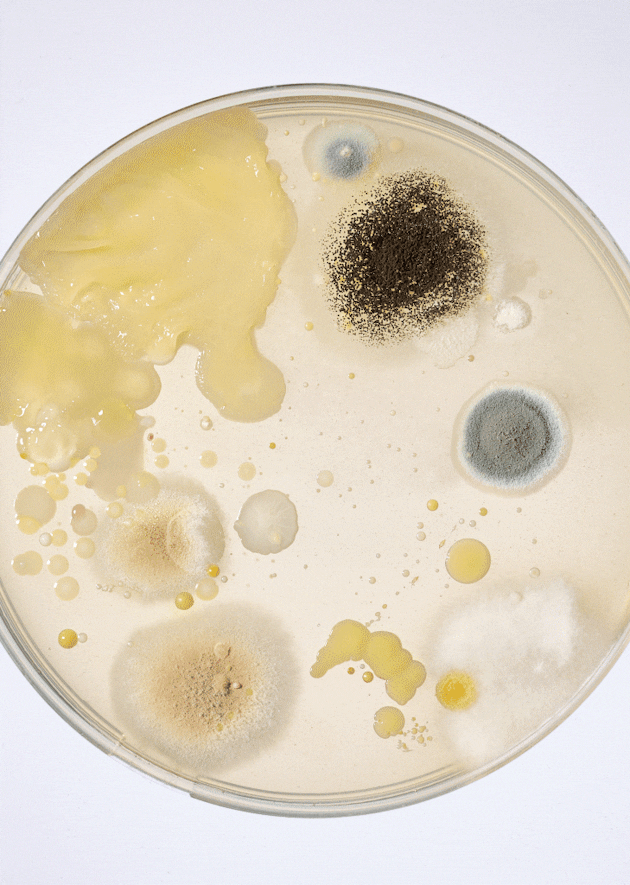
No alternate text
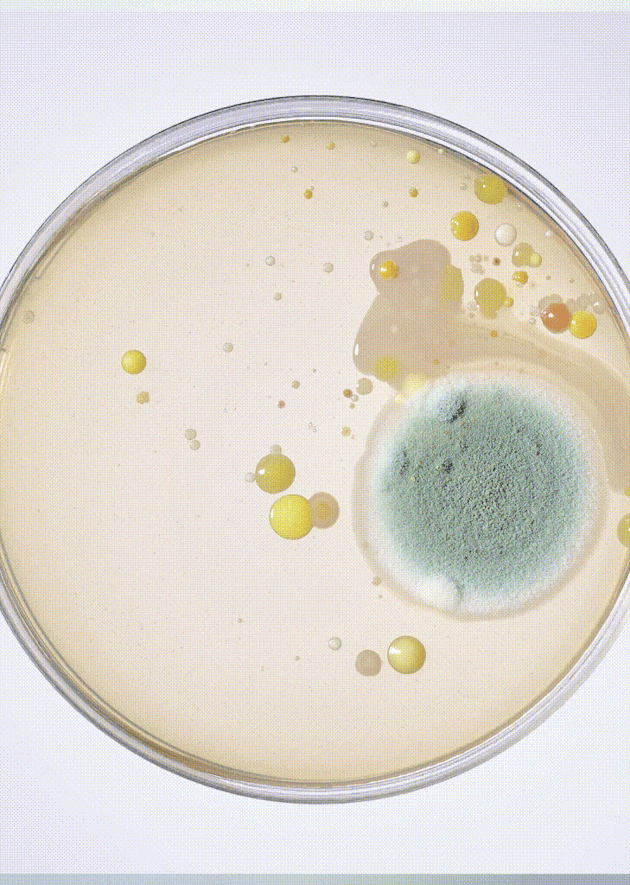
No alternate text
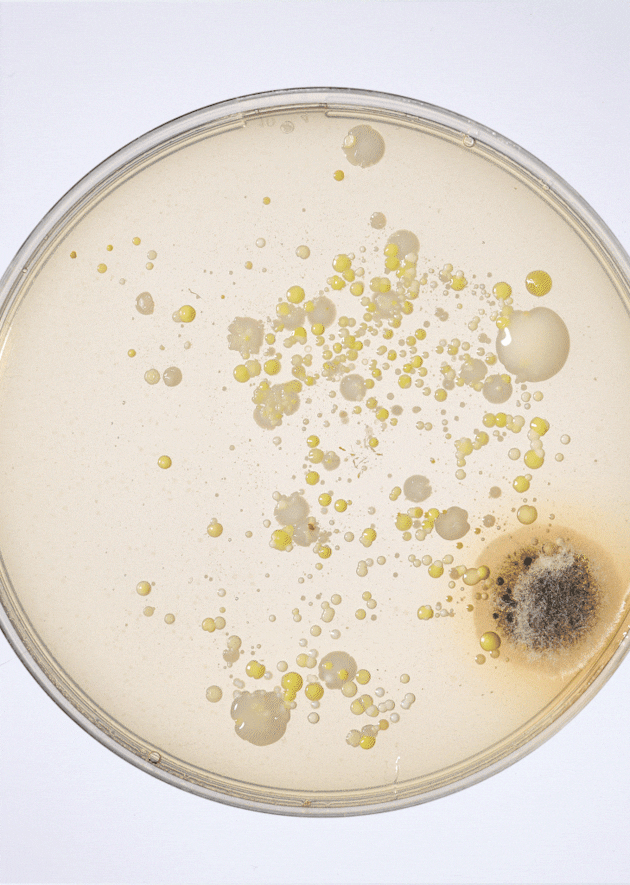
No alternate text
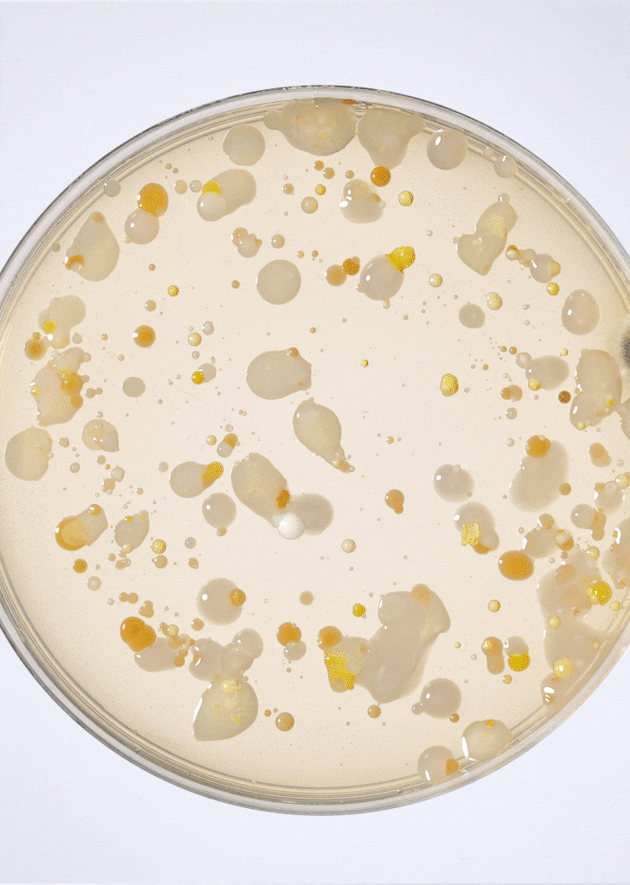
No alternate text
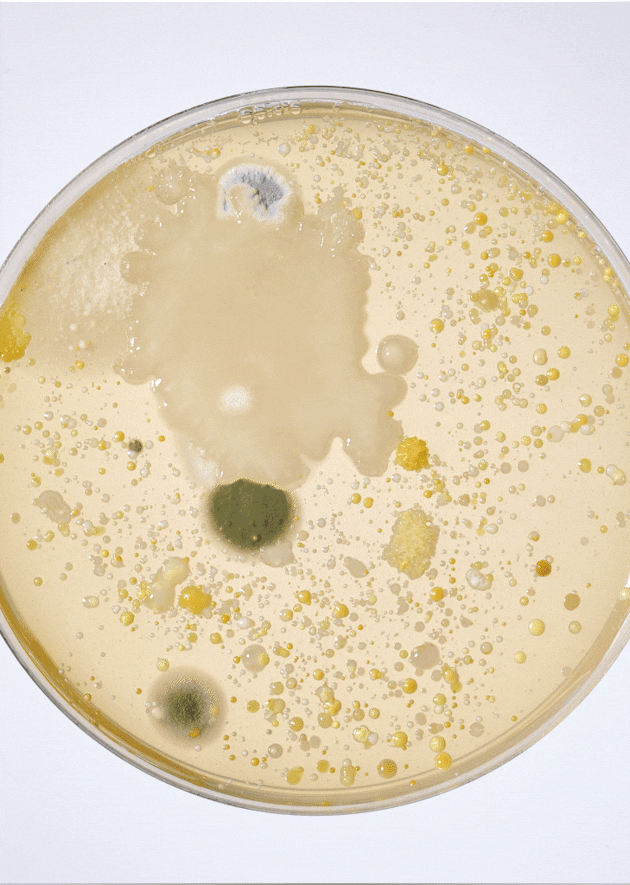
No alternate text
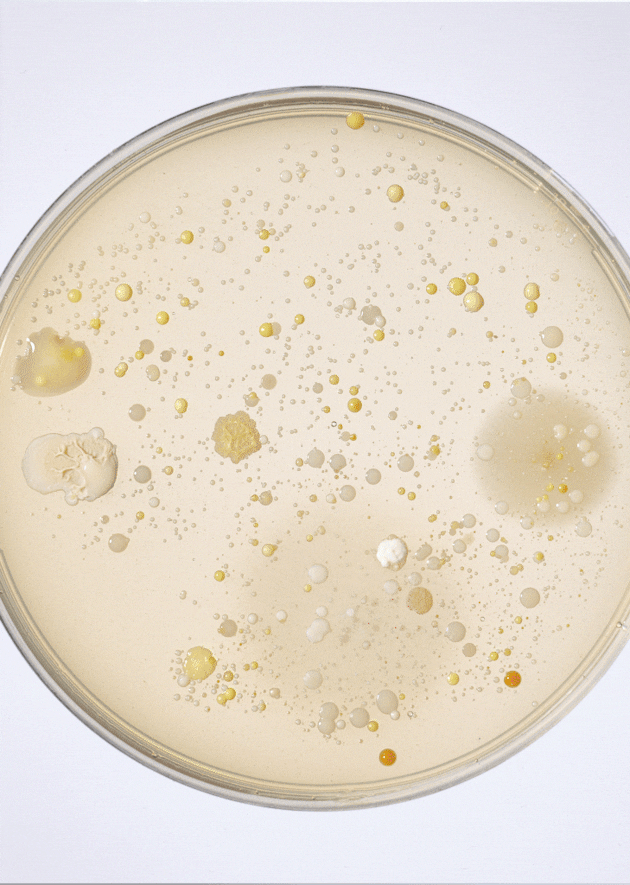
No alternate text

WE ARE ZORBA
infused by Science, Moved by Art, Powered by Tech.
WE ARE A TEAM OF SCIENTIFIC MARKETERS
working hand-in-hand with
ARTISTS – CREATIVES – PRODUCERS

We master every type of science, in every possible field.
Personal care, pharma and medical devices, technical fashion… no matter the field our team of scientists, ranging from pharmacists to biotechnologists, bridge the gap between R&D and Marketing departments to unfold truly memorable and engaging scientific stories.
They collaborate directly with R&D teams to digest their science – from pharmacology & physiopathology to technical plans or clinical studies – and turn it into clear and simple messages. Together with our strategists and creatives, they upgrade them into claims and memorable stories, and ensure their accuracy all along our fully-integrated process, from creation up to post-production.
WE BLEND TALENTS
to unfold never-seen-before scientific stories or experiences
At Zorba, our strength lies in our diversity:
our many talents constantly challenge themselves
to master the art of talking to audiences.
Together, they craft bold & proprietary creative answers.
Meet our multi-skilled team.
Meet our multi-skilled team
Why
choose us
Whatever your needs are, there is a Zorba team for you!

Our values
at Zorba






Get in touch with us
to learn more